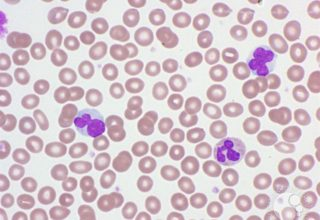

Paula Sánchez ejercicio 24
jueves, 3 de diciembre de 2020
viernes, 30 de octubre de 2020
TINCIÓN GIEMSA
LAURA CREGO GARCÍA
| EXTRAN NEUTRO. Los detergentes de lavado a mano se proporcionan concentrados y la limpieza se llevan a cabo con agua corriente. La habitual inmersión de 2 horas es suficiente; no obstante, este periodo de tiempo puede ser mayor con residuos especialmente difíciles. dicorlab.com |
TINCIÓN MAY GRÜNWALD-GIEMSA NEUTRÓFILO ABAJO Y LINFOCITO ARRIBA
LAURA CREGO GARCÍA
| La tinción de May Grünwald-Giemsa o Pappenheim es una técnica de coloración diferencial que mezcla los reactivos Giemsa y May Grünwald. Es utilizada para la diferenciación de células sanguíneas normales y anormales en frotis de sangre periférica y médula ósea, así como para la tinción de cortes histológicos y muestras citológicas. www.lifeder.com |
jueves, 5 de marzo de 2020
miércoles, 4 de marzo de 2020
Suscribirse a:
Entradas (Atom)